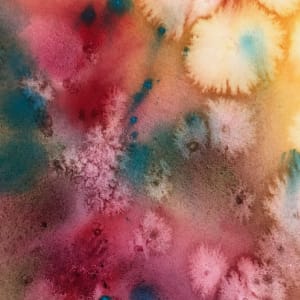
So Many Flowers! - Drawing a Day #160 by Helen R Klebesadel

#160 of my 2024 'Drawing A Day for Good' series. I decided to do the 'Drawing A Day' project in 2024, offering an unframed watercolor and ink artwork for sale each day at the price of $100. The profits are donated to good causes that I choose.
Lately I have been drawing almost every day as a visual meditation. I draw with ink into the watercolor teaching samplers that I created while teaching watercolor workshops. When I sit down to draw into the small loose watercolors, I look at the simple paintings and enhance the image by drawing into it with inks.
Here I drew into it with black ink and finished the flowers and grass with white ink. (You can also see an image of the watercolor before I drew inti it).
Because most of my professional paintings take a month or more to create, these drawings, usually done in one sitting, have become a real source of pleasure. I consider them active meditations.
I originally planned to do the project for at least 30 days but I have decided to continue for a while longer since its still fun. Let's see how long I can keep this up...
- Subject Matter: Still Life
- Collections: Drawing For Good, Collected Artworks, Watercolor and Ink